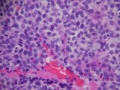
Thumbnail for version as of 18:59, June 1, 2011

File:Rhabdo Figure 6.jpg
From EyeWiki
Rhabdo_Figure_6.jpg (800 × 600 pixels, file size: 121 KB, MIME type: image/jpeg)
Fig 6. Hematoxylin and eosin stain, 400X magnification, cells with highly eosinophilic cytoplasm and hyperchromatic nuclei. (From Burkat CN, Lucarelli MJ: Rhabdomyosarcoma masquerading as acute dacryocystitis. Ophthal Plast Reconstr Surg. 2005 Nov; 21(6):456-8).
File history
Click on a date/time to view the file as it appeared at that time.
| Date/Time | Thumbnail | Dimensions | User | Comment | |
|---|---|---|---|---|---|
| current | 18:59, June 1, 2011 | | 800 × 600 (121 KB) | Cat.N.Burkat (talk | contribs) | Fig 6. Hematoxylin and eosin stain, 400X magnification, cells with highly eosinophilic cytoplasm and hyperchromatic nuclei. (From Burkat CN, Lucarelli MJ: Rhabdomyosarcoma masquerading as acute dacryocystitis. Ophthal Plast Reconstr Surg. 2005 Nov; 21(6): |
You cannot overwrite this file.
File usage
The following page uses this file:


